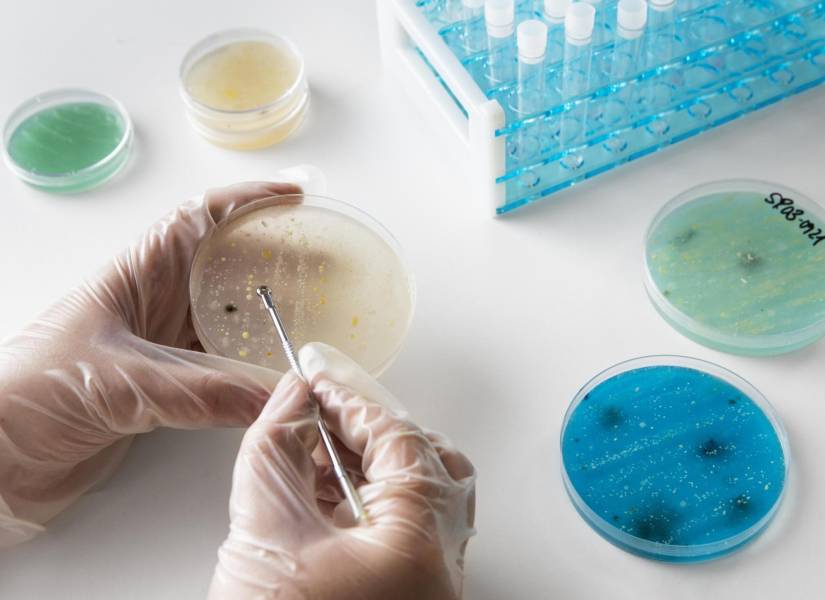
Persona realizando un estudio en un laboratorio

Microplásticos en testículos humanos, un potencial riesgo para la salud reproductiva
Un estudio reciente ha descubierto microplásticos en testículos humanos, sugiriendo una posible relación con la disminución del conteo espermático.
-
 Persona en laboratorio haciendo experimentos de cerca( )
Persona en laboratorio haciendo experimentos de cerca( )
Un reciente estudio ha revelado la presencia de microplásticos en testículos humanos, sugiriendo una posible relación con la disminución de la cuenta espermática en hombres a nivel global. Este hallazgo, publicado en la revista Toxicological Sciences, indica que los niveles más altos de contaminación por microplásticos se correlacionan con una menor producción de esperma, aunque se requiere más investigación para establecer una conexión causal definitiva.
Los científicos examinaron 23 testículos humanos y 47 testículos de perros domésticos, encontrando microplásticos en cada muestra. Los testículos humanos provinieron de autopsias realizadas en 2016 a hombres cuyas edades oscilaban entre los 16 y los 88 años.
Lea: Los mayores contaminadores de plástico en el mundo, según un estudio global
Los testículos de perros fueron obtenidos de prácticas veterinarias que realizaron operaciones de castración. Los resultados mostraron que las muestras con mayores niveles de PVC en los perros tenían una cuenta espermática inferior.
¿Qué se descubrió en este estudio?
El estudio descubrió que los niveles de concentración de microplásticos en los testículos humanos eran casi tres veces superiores a los encontrados en los testículos caninos, con 330 microgramos por gramo frente a 123 microgramos por gramo. El polietileno, utilizado comúnmente en bolsas y botellas de plástico, fue el microplástico más prevalente, seguido por el PVC.
Yu, uno de los investigadores, comentó que "el impacto en las generaciones más jóvenes podría ser más preocupante", debido a la creciente presencia de plásticos en el medio ambiente. Este estudio se suma a la creciente evidencia de la contaminación generalizada por microplásticos, que ya han sido encontrados en la sangre humana, placentas y leche materna.
Lea: Artritis: cuáles son las causas y los tratamientos de esta enfermedad
Impacto de los microplásticos en la salud humana
Aunque el impacto total de los microplásticos en la salud humana aún no se comprende completamente, estudios en laboratorio han demostrado que estas partículas pueden dañar células humanas. Los microplásticos pueden aumentar el riesgo de infartos de miocardio, accidentes cerebrovasculares y provocar inflamación de los tejidos.
El estudio utilizó una técnica que disolvió las muestras de tejido para luego analizar los plásticos restantes. Estos nuevos hallazgos podrían respaldar la teoría de que los microplásticos contribuyen al descenso global del recuento de espermatozoides. Además, la contaminación por microplásticos podría tener implicaciones mucho más amplias para la salud pública.
Recomendadas


